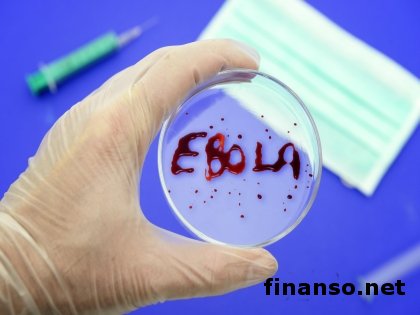

В США начались испытания вакцины от Эболы на людяхКатегория: Технологии
Будучи серьезно обеспокоенными сложившейся ситуацией по распространению вируса Эбола, случаи заболевания которым зарегистрированы наряду с Африкой и на других континентах, набрав первую группу добровольцев, по сведениям печати, запустили испытания канадской вакцины против лихорадки Эбола американские специалисты. Об этом сообщают корреспонденты издания «Украина сегодня: Finanso.net». Будучи серьезно обеспокоенными сложившейся ситуацией по распространению вируса Эбола, случаи заболевания которым зарегистрированы наряду с Африкой и на других континентах, набрав первую группу добровольцев, по сведениям печати, запустили испытания канадской вакцины против лихорадки Эбола американские специалисты. Об этом сообщают корреспонденты издания «Украина сегодня: Finanso.net».Тринадцатого октября была введена людям первая порция этой вакцины, и, по сообщению руководителя Минздрава Канады, информации о действии этого лекарственного вещества пока нет. Свою эффективность вакцина показала в испытаниях на животных.По заявлению госчиновника, вакцина оказалась очень эффективной, показав себя с нужной стороны в прошедших испытаниях, с участием лабораторных животных. Новое вещество облегчает течение болезни, защищает от заражения, увеличивая также шанс заболевших на выживание. Весь мир включился в борьбу с этой инфекцией, а смертельных случаев от заболевания лихорадкой Эбола на сегодняшний день зарегистрировано больше четырех тысяч. Напомним, что американские и британские ученые провели на обезьянах успешные испытания вакцины против лихорадки Эбола, опубликовав эти данные в одном из научных журналов. Одной из самых опасных и страшных болезней современности стала лихорадка Эбола, а первые сведения об этом вирусе появились в 1970 г. До последнего времени вакцины против возбудителя этого заболевания не было, смертность от которого достигает огромных цифр при заражении. Крупные фармацевтические компании в разработку указанной вакцины не вкладывали много средств, поскольку названное заболевание встречалось довольно редко, однако его опасность уже подтверждается гибелью до тысячи человек в год. На шимпанзе были проведены испытания вакцины против этого вируса американскими учеными вместе с их британскими коллегами. Предполагалось, что разработанную вакцину можно будет использовать также и для человека, поскольку она формировала безопасный и стойкий иммунитет у животных. Восемьдесят три жизни унесла последняя вспышка лихорадки Эбола в Гвинее, где до сих пор растет число ее жертв. В Сьерра-Леоне, Мали и Либерии также были замечены случаи заболевания этим вирусом. Относясь к особо опасным инфекционным заболеваниям, лихорадка Эбола в большинстве случаев заканчивается смертью заболевшего человека,о чем сообщалось в СМИ. |
Автор: Александр Павлов
Уважаемый посетитель, Вы зашли на сайт как незарегистрированный пользователь. Мы рекомендуем Вам зарегистрироваться либо зайти на сайт под своим именем.



